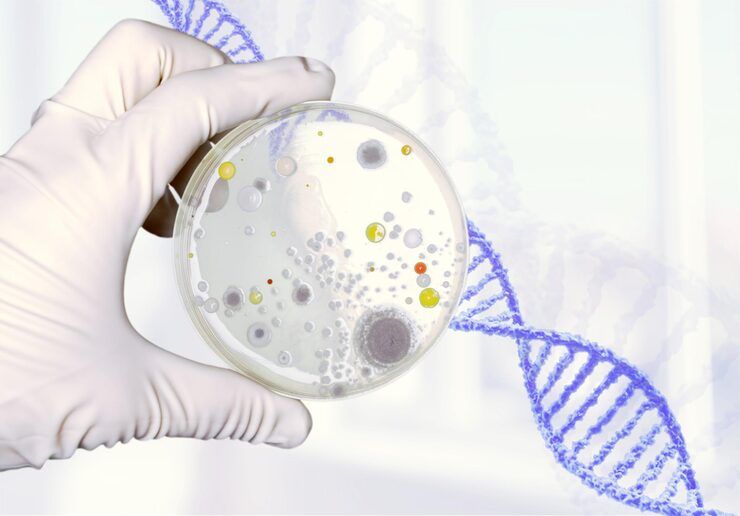
Antibody Development

Antibody development is a scientific process used to create antibodies that can recognize and bind to specific targets, known as antigens. These targets are often proteins, pathogens, or abnormal cells. Antibodies play a crucial role in the immune system, and scientists harness this ability for research, diagnostics, and therapeutic applications.
The purpose of antibody development is to produce highly specific and reliable molecules that can detect or neutralize biological targets. This is especially important in areas such as disease diagnosis, drug discovery, and biotechnology research.
Antibody development follows a structured workflow that involves identifying a target, generating antibodies, and validating their effectiveness.
The process typically includes:
Modern approaches often rely on recombinant DNA technology, enabling precise control over antibody design and production.
Antibodies, also known as immunoglobulins, have a characteristic Y-shaped structure. This structure allows them to bind specifically to antigens.
Key structural components include:
Different classes of antibodies (IgG, IgM, IgA, IgE, IgD) serve various roles in the immune system.
Antibody development is essential in modern science and healthcare due to its wide range of applications.
It helps in:
Without antibody development, many diagnostic tools and treatments would not exist.
Antibody development has practical applications across multiple industries.
These applications highlight the versatility and importance of antibodies in solving real-world problems.
Different types of antibodies are developed based on specific needs and applications.
Each type has unique advantages depending on the use case.
Antibody development involves several important features that determine quality and performance.
These factors are critical in ensuring reliable results in both research and clinical settings.
Antibody development continues to evolve with advancements in technology and research.
These innovations are making antibody development faster, more precise, and more scalable.
Antibody development, especially for therapeutic use, is regulated to ensure safety and effectiveness.
Regulatory compliance is essential for bringing antibody-based solutions into practical use.
Several tools and platforms support antibody development and related research.
These resources help researchers design, analyze, and optimize antibodies effectively.
| Step | Description | Outcome |
|---|---|---|
| Antigen Selection | Identify target molecule | Defined research focus |
| Immunization | Stimulate immune response | Antibody-producing cells |
| Screening | Identify effective antibodies | High-specificity candidates |
| Validation | Test performance and reliability | Verified antibodies |
| Production & Purification | Scale up and refine antibodies | Ready-to-use antibodies |
Despite its benefits, antibody development faces several challenges:
Addressing these challenges is a major focus of ongoing research.
The future of antibody development is promising, with continued integration of advanced technologies.
Expected advancements include:
These developments will likely expand the impact of antibodies in healthcare and science.
Antibody development is used for diagnostics, therapeutic treatments, and scientific research involving specific target detection.
Monoclonal antibodies are identical antibodies produced from a single cell line, designed to bind a specific antigen.
The process can take several weeks to months, depending on the method and complexity.
Monoclonal antibodies target a single epitope, while polyclonal antibodies recognize multiple epitopes on the same antigen.
High specificity ensures accurate targeting, reducing errors in diagnostics and improving treatment effectiveness.
Antibody development is a cornerstone of modern biotechnology and medical research. By enabling precise targeting of biological molecules, it supports advancements in diagnostics, therapeutics, and scientific discovery. With continuous innovation in areas like artificial intelligence, genetic engineering, and molecular biology, the field is evolving rapidly.
As new technologies emerge, antibody development will continue to play a vital role in addressing complex health challenges and expanding our understanding of biological systems.
Disclaimer: The information provided in this article is for informational purposes only. We do not make any claims or guarantees regarding the accuracy, reliability, or completeness of the information presented. The content is not intended as professional advice and should not be relied upon as such. Readers are encouraged to conduct their own research and consult with appropriate professionals before making any decisions based on the information provided in this article.
By:
Updated: April 16, 2026
Read More